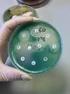
Integrazione di metodiche sierologiche e molecolari per la tipizzazione del donatore e del ricevente

Le problematiche dei gruppi sanguigni rari
|
|
|
- Gianfranco Deluca
- 10 anni fa
- Просмотров:
Транскрипт
1 Le problematiche dei gruppi sanguigni rari Laboratorio di Immunoematologia Centro Trasfusionale e di Immunoematologia dei Trapianti Fondazione IRCCS Ospedale Maggiore Policlinico - Milano
2 Perché nasce l'esigenza di istituire una Banca di Sangue Raro? La Banca di Sangue Raro è essenziale per far fronte a richieste di sangue nei casi di complessa immunizzazione
3 Soggetti sottoposti a frequenti trasfusioni Pazienti affetti da patologie ereditarie (talassemia, sickle-cell disease) Pazienti affetti da patologie acquisite (anemia emolitica autoimmune, patologie ematologiche, neoplasie)
4 Cos è il sangue raro? Per sangue raro si intende un tipo di sangue che possiede una combinazione di antigeni non comune La frequenza del fenotipo raro nei donatori è molto bassa negativi per combinazione di antigeni multipli dei sistemi comuni (1:1000-1:5000) negativi per antigeni ad alta incidenza, estremamente rari (<1:5000 ) Donatori di sangue raro rappresentano una risorsa per tutta la comunità Standards: American Rare Donor Program (ARDP), Council of Europe, International Donor Panel (IDP), International Society of Blood Transfusion (ISBT), Council of Europe, Japanese Red Cross
5 Donatori di gruppo raro per combinazione di antigeni multipli Gruppo A e 0 KEL RH KIDD DUFFY MNS K-k+ CCDee ccdee ccdee ccdee Jk(a+b-) Jk(a-b+) Fy(a+b-) Fy(a-b+) S-s+ S+s- Rari Molto rari
6 Hh JMH VEL Ok O h SISTEMA FENOTIPO RH CCDEE, CCdee, ccdee, CCdEE, delezioni KEL Ko, Kvar, Kp(b-), Js(b-), k- JK Jk(a-b-) FY Fy(a-b-) LW LW(a-), LW(a-b-) DO Hy-, Gy(a-), Jo(a-) IN In(b-) MNS U-, En(a-), S-s- CO Co(a-b-), Co(a-) LU Lu(a-b-), Lu(b-) SC Sc:-1, Sc:-1,-2 GE Ge:-2, Ge:-2,-3, Ge:-2,-3,-4 CROM Cr(a-), Es(a-), Tc(a-), Dr(a-), IFC-, WES(b-), UMC YT Yt(a-) DI Di(b-), Wr(b-) 901 Serie Lan-, At(a-), Jr(a-), Emm-, AnWj- GLOB PP 1 P k -, P-, LKE- JMH- Vel- Ok(a-) Donatori estremamente rari negativi per antigeni ad alta incidenza Tutti i gruppi AB0 e i fenotipi Rh
7 Distribuzione dei gruppi rari in alcune aree geografiche Vel-, Yt(a-), LW(a-) Di(b-), Jr(a-) Jk(a-b-), Oh Wr(b-), Es(a-), En a FR-, Yt(a-), Di(b-), Ge:-2,-3 U-, hrs-, hrb-, Lu:-8, Js(b-), Fy(a-b-), Hy- At(a-), Jo(a-), Cr(a-), Tc(a-), Sl(a-) Ge:-2,-3, Globo:-1,-2
8 Il reperimento di sangue può essere molto difficile quando un paziente con anticorpi multipli possiede un assetto antigenico molto raro specifico per una comunità
9 Gruppo raro Gruppo raro Quando è presente un gruppo raro solo pochi donatori possono donare il sangue ad un paziente con anticorpi
10 Migrazioni e problematiche trasfusionali La crescente immigrazione presente in Italia comporta lo sviluppo progressivo di una società multietnica. Nelle società multietniche il numero di pazienti di etnie diverse in possesso di gruppi sanguigni rari è molto elevato. La consistenza numerica degli immigrati stranieri presenti in Lombardia è passata dai 420mila individui del 1 gennaio 2001 al milione e 170mila del 1 luglio 2009 (dati ORIM). I soggetti stranieri provengono per la maggior parte dall Europa Centro-Orientale, dall Africa settentrionale e centrale, da alcuni Paesi asiatici e dall America centro-meridionale.
11 Extracomunitari residenti in Italia per paese di provenienza (dati ISTAT 2010)
12 Extracomunitari residenti in Italia per paese di provenienza N
13 Alcune di queste popolazioni sono caratterizzate dall assenza di fenotipi ad alta incidenza o da specifiche combinazioni di antigeni comuni (ben rappresentati invece nella popolazione di donatori di sangue caucasici prevalenti nel territorio) e devono quindi essere considerate ad elevato rischio di immunizzazione post-trasfusionale. La maggior probabilità di immunizzazione è correlata anche all elevata diffusione di alcune malattie ematologiche, come la drepanocitosi e la talassemia che richiedono un supporto trasfusionale continuo (la percentuale di immunizzazione posttrasfusionale nei soggetti politrasfusi affetti da queste patologie risulta essere tra il 29% e il 72% in base all etnia considerata).
14 La diversa composizione etnica del territorio rappresenta un potenziale problema trasfusionale per il reperimento di unità di gruppo raro compatibili per i soggetti immunizzati. Negli individui di etnia africana sono frequentemente osservati anticorpi diretti verso i sistemi KEL, KIDD, DUFFY, MNS: in alcune popolazioni nel 12% dei soggetti sono contemporaneamente assenti i corrispondenti antigeni, contro una percentuale inferiore all 1% nelle persone di etnia caucasica. Inoltre nei soggetti di etnia africana è stata riscontrata più frequentemente rispetto ai caucasici l assenza di alcuni antigeni Rh ad alta incidenza e la presenza di varianti Rh(D). Anche i soggetti con questi assetti possono immunizzarsi quando trasfusi con sangue di soggetti di un altra etnia positivi per l antigene.
15 In Italia i donatori di sangue sono ancora quasi tutti di origine italiana: solo il 2,4% dei nostri donatori è straniero mentre la popolazione straniera nel territorio circostante tocca il 15%. I donatori stranieri sono scarsamente rappresentati nella nostra regione.
16 Vanno attuate strategie mirate per incoraggiare la donazione delle minoranze etniche sollecitando il superamento di barriere culturali e la crescita della solidarietà sociale Ad esempio gli Afroamericani, affetti da falcemia, trasfusi con sangue di donatori di origine europea, sono le persone più pesantemente immunizzate al mondo. Trovare del sangue compatibile diventa spesso una difficile impresa ed alle volte non è possibile sottoporli a questa terapia, con conseguenze facilmente intuibili.
17 E importante rendere consapevoli queste popolazioni dei problemi a cui possono andare incontro. Ciò sarà anche strumento forte di integrazione sociale e contribuirà a consolidare le nostre risorse trasfusionali a volte scarse.
18 Le nostre iniziative per la donazione di sangue nelle comunità straniere Abbiamo avviato iniziative di promozione specifiche rivolte agli stranieri Principali comunità coinvolte: srilankesi, latinoamericani, filippini e africani Punti chiave per il successo: contatti con i nostri donatori stranieri sostegno di figure leader nelle comunità e nelle celebrazioni partecipazione ad eventi delle comunità
19
20 Registri di donatori di gruppo raro e banche di sangue raro European Bank of Frozen Blood Council of Europe Amsterdam New York Blood Center ARDP American Rare Donor Program Philadelphia WHO IDP Bristol BNSPR Banque Nationale de Sang de Paris Shanghai Blood Center Japan Red Cross Natal Blood Transfusion Service
21 La Banca di Emocomponenti di Gruppi Rari Centro di Riferimento della Regione Lombardia Attiva da Gennaio 2005 In base alla convezione stipulata con la Regione, la Banca ha sede presso la Fondazione IRCCS Cà Granda Ospedale Maggiore Policlinico di Milano Il progetto è stato rinnovato anche per il triennio e coinvolge 15 DMTE lombardi
22 La costituzione di una Banca di Emocomponenti di Gruppo Raro è un obiettivo che per essere realizzato richiede: Un ingente impegno economico della Regione o dello Stato Un elevato grado di specializzazione del laboratorio di immunoematologia Una collaborazione da parte di tutti gli attori della rete trasfusionale del territorio
23 Obiettivi della Banca Identificare donatori di gruppo sanguigno raro per antigeni eritrocitari e piastrinici Gestire le unità congelate di gruppo sanguigno raro della Regione Lombardia Allestire un Registro Regionale di donatori rari Allestire un laboratorio di immunoematologia in grado di eseguire indagini di II livello e studiare casi di complessa immunizzazione eritrocitaria e piastrinica Gestire richieste di unità di gruppo raro per soggetti con quadri di complessa immunizzazione
24 Criteri di inclusione dei donatori Età Gruppi sanguigni Fenotipi Rh 55 anni 0 e A CCDee, ccdee, ccdee, ccdee N. di donazioni > 2
25 Rinnovo delibera Banca degli Emocomponenti di Gruppo Raro (triennio ) Mantenimento dell inventario di unità a fenotipo raro con la tipizzazione eritrocitaria e piastrinica di altri donatori di sangue Costituzione di un registro di donatori IgA-carenti screening di circa donatori maschi di gruppo AB selezionati da tutti i DMTE Regionali) per soddisfare le esigenze trasfusionali dei pazienti con deficit di IgA Completamento dell inventario di unità a fenotipo raro con tipizzazione mirata in donatori di etnia non caucasica
26 Perché introdurre la biologia molecolare in immunoematologia? Aumenta la disponibilità di donatori estensivamente tipizzati Fornisce un fenotipo esteso per pazienti immunizzati al DNA dall agglutinazione...
27 Quale tecnica di biologia molecolare ad alta produttività abbiamo scelto?
28 Sistemi di 11 gruppi sanguigni Antigeni Rh C, c, E, e KEL K, k, Js a Js b, Kp a Kp b Kidd Jk a Jk b Duffy Fy a Fy b, Fy x, GATA MNS M, N, S, s, U, U var Dombrock Do a Do b, H y, Jo a Lutheran Lu a Lu b Landsteiner Wiener Lw a Lw b Diego Di a Di b Colton Co a Co b Scianna Sc1/2 + 1 spot per il riconoscimento dell HbS HEA 33 antigeni polimorfici eritrocitari
29 Antigeni HPA-1(a/b) HPA-2(a/b) HPA-3(a/b) HPA-4(a/b) HPA-5(a/b) HPA-6(a/b) HPA-7(a/b) HPA-8(a/b) HPA-9(a/b) HPA-11(a/b) HPA-15(a/b) HPA 22 antigeni polimorfici piastrinici
30 Fasi di lavoro Tipizzazioni di I livello eseguite in biologia molecolare con l impiego di una tecnologia ad elevata produttività (MicroArray) Conferma delle tipizzazioni in sierologia con lo strumento Galileo Immucor Conferma delle tipizzazioni o eventuali discrepanze con SSP-PCR (BaGene e Innotrain) e ASP-PCR (ThromboType - GTI)
31 Rendiconto totale attività banca Sono stati tipizzati donatori ed identificati donatori rari per combinazione di antigeni eritrocitari in tutta la Regione Lombardia 422 donatori identificati rari per antigeni ad alta incidenza 33 donatori identificati rari per fenotipo Rh donatori rari per antigeni piastrinici
32 Donatori rari identificati per antigeni eritrocitari 3115; 39% 422; 5% 33; 0% 802; 10% 934; 12% : No ; 34% S+ s- gr.a S+ s- gr.0 S- s+ gr.a S- s+ gr. 0 Alta incidenza Fenotipo
33 Donatori identificati rari per antigeni ad alta incidenza dal 2005 al 2010 Donatori identificati rari per fenotipo Rh dal 2005 al 2010 Specificità Numerosità Co(a-b+) 36 Fy(a-b-) 70 Fy(a-b-)/hr(B-) 1 Fy(a-b-)/Js(b-) 3 Fy(a-b-)/U- 1 Ge:-2 3 Specificità Numerosità k- 90 Kp(a+b-) 2 Lu(a+b-) 34 Lu(a-b-) 30 PP 1 P k - 1 Vel- 10 Fenotipo CCdee 18 ccdee 7 CCDEE 6 --D-- 2 Totale 33 Numerosità Jk(a-b-) 1 Yt(a-) 137 Totale: 422
34 Donatori rari identificati per antigeni piastrinici Aprile : No ; 9% 360; 14% 188; 7% 1846; 70% HPA-1a HPA-2a HPA-3a HPA-5a
35 Casi di complessa immunizzazione Suddivisione dei casi di complessa immunizzazione Complessa alloimmunizzazione eritrocitaria (miscele di anticorpi verso antigeni comuni) 131 Complessa alloimmunizzazione eritrocitaria (anticorpi verso antigeni ad alta incidenza) 41 Alloimmunizzazione eritrocitaria(anticorpi verso antigeni a bassa incidenza) 12 Autoimmunizzazione eritrocitaria 63 Miscela di allo autoimmunizzazione eritrocitaria 52 Identificazione varianti AB0 ed Rh 160 Identificazione anticorpi anti-piastrine 94 Sospetta NAITP 26 Identificazione anticorpi eparina dipendenti 95 Altro 48 Totale 722 Totale ( )
36 Attività di congelamento/scongelamento di unità di gruppo raro Totale Totale unità congelate per alta incidenza 517 per combinazione d antigeni 170 Totale unità scongelate per alta incidenza 108 per combinazione d antigeni 113 Dall inizio dell attività sono state congelate 933 unità.
37 Tabella confronto inventario CTI (Lombardia), National Frozen Blood Bank (Bristol - UK), Frozen Blood Council (UE) Antigene raro National Frozen Blood Bank (UK) Frozen Blood Council/Europe Banca Rari Lomabardia Oh CDE/CDE CdE/CdE C w D-/C w D D-/-D Rh null Rh: LW(a-b+) LW(a-b-) S-s-U S-s-U(+) pp Pk Lu(a+b-) Lu(a-b-) Kp(a+b-) Kp(a-b-) Js(a+b-) Ko K: Fy(a-b-) Jk(a-b-) Di(b-) Sc: Co(a-) Co(a-b-) Do(a-) Vel Ge Lan Jr(a-) k Yt(a-)
38 Hanno collaborato DMTE della Regione Lombardia Associazioni dei donatori di sangue della Regione Lombardia
39 Grazie per l attenzione
Il doppio valore del dono e dell integrazione
 Il doppio valore del dono e dell integrazione La rete del progetto Il sangue non ha colore è un progetto promosso da ANOLF Lecco e AVIS comunale di Lecco. ANOLF si appoggia ad AVIS per promuovere l iniziativa
Il doppio valore del dono e dell integrazione La rete del progetto Il sangue non ha colore è un progetto promosso da ANOLF Lecco e AVIS comunale di Lecco. ANOLF si appoggia ad AVIS per promuovere l iniziativa
Relazione Dr.ssa Cinzia Paccapelo. Caratteristiche immunoematologiche delle popolazioni locali
 Relazione Dr.ssa Cinzia Paccapelo Caratteristiche immunoematologiche delle popolazioni locali Antigeni dei gruppi sanguigni: classificazione (1) N. Simbolo Localizzazione 001 ABO 9q34.2 002 MNS 4q31.21
Relazione Dr.ssa Cinzia Paccapelo Caratteristiche immunoematologiche delle popolazioni locali Antigeni dei gruppi sanguigni: classificazione (1) N. Simbolo Localizzazione 001 ABO 9q34.2 002 MNS 4q31.21
Integrazione di metodiche sierologiche e molecolari per la tipizzazione del donatore e del ricevente
Integrazione di metodiche sierologiche e molecolari per la tipizzazione del donatore e del ricevente Dott. ssa M. Antonietta Villa Centro Trasfusionale e di Immunoematologia Dipartimento di Medicina Rigenerativa
Integrazione di metodiche sierologiche e molecolari per la tipizzazione del donatore e del ricevente Dott. ssa M. Antonietta Villa Centro Trasfusionale e di Immunoematologia Dipartimento di Medicina Rigenerativa
Direttore Dr.ssa Tiziana Riscaldati. SIMT-POS 027 Analisi Immnunoematologiche
 1 1 2 1 SCOPO Scopo della presente procedura è quello di illustrare le analisi immunoematologiche che vengono effettuate presso il SIMT andando a descrivere le modalità attraverso le quali vengono gestite.
1 1 2 1 SCOPO Scopo della presente procedura è quello di illustrare le analisi immunoematologiche che vengono effettuate presso il SIMT andando a descrivere le modalità attraverso le quali vengono gestite.
Registro delle associazioni e degli enti che operano a favore degli immigrati - Prima sezione Attività 2014
 Direzione Generale dell Immigrazione e delle Politiche di Integrazione Divisione II Registro delle associazioni e degli enti che operano a favore degli immigrati - Prima sezione Attività 2014 A cura della
Direzione Generale dell Immigrazione e delle Politiche di Integrazione Divisione II Registro delle associazioni e degli enti che operano a favore degli immigrati - Prima sezione Attività 2014 A cura della
Il valore generato dal teatro alla Scala
 Il valore generato dal teatro alla Scala Paola Dubini Centro ASK Università Bocconi Sintesi dei risultati Nello scorso mese di gennaio, il teatro alla Scala ha affidato al centro ASK dell Università Bocconi
Il valore generato dal teatro alla Scala Paola Dubini Centro ASK Università Bocconi Sintesi dei risultati Nello scorso mese di gennaio, il teatro alla Scala ha affidato al centro ASK dell Università Bocconi
Esami di qualificazione biologica su ogni donazione
 Esami di qualificazione biologica su ogni donazione HCV Ab, HCV-RNA (da giugno 2002) HIV 1-2 Ab, HIV1-RNA (da giugno 2008) HBsAg, HBV-DNA (da giugno 2008) Sierodiagnosi per la lue Decreto Ministro della
Esami di qualificazione biologica su ogni donazione HCV Ab, HCV-RNA (da giugno 2002) HIV 1-2 Ab, HIV1-RNA (da giugno 2008) HBsAg, HBV-DNA (da giugno 2008) Sierodiagnosi per la lue Decreto Ministro della
Sabato 17 ottobre 2015 S. Beux, S. Monticone, G. Innocenzi, M. Zaffaroni, G. Bona
 Sabato 17 ottobre 2015 S. Beux, S. Monticone, G. Innocenzi, M. Zaffaroni, G. Bona Clinica Pediatrica Università degli Studi di Novara A.O.U. Maggiore della Carità di Novara Nel Mondo: 130-150 milioni di
Sabato 17 ottobre 2015 S. Beux, S. Monticone, G. Innocenzi, M. Zaffaroni, G. Bona Clinica Pediatrica Università degli Studi di Novara A.O.U. Maggiore della Carità di Novara Nel Mondo: 130-150 milioni di
QUALITÀ E SICUREZZA PER I NOSTRI PAZIENTI
 QUALITÀ E SICUREZZA PER I NOSTRI PAZIENTI L ACCREDITAMENTO INTERNAZIONALE ALL ECCELLENZA Fondazione Poliambulanza ha ricevuto nel dicembre 2013 l accreditamento internazionale all eccellenza da parte di
QUALITÀ E SICUREZZA PER I NOSTRI PAZIENTI L ACCREDITAMENTO INTERNAZIONALE ALL ECCELLENZA Fondazione Poliambulanza ha ricevuto nel dicembre 2013 l accreditamento internazionale all eccellenza da parte di
XV CONGRESSO NAZIONALE SIdEM Torino, 9-12 novembre 2011
 XV CONGRESSO NAZIONALE SIdEM Gestione Appropriata ed Integrata dei Test Sierologici e Molecolari nel Laboratorio di Immunoematologia di II Livello Antonella Matteocci U.O.C. SIMT Ospedale San Camillo ROMA
XV CONGRESSO NAZIONALE SIdEM Gestione Appropriata ed Integrata dei Test Sierologici e Molecolari nel Laboratorio di Immunoematologia di II Livello Antonella Matteocci U.O.C. SIMT Ospedale San Camillo ROMA
DONAZIONE SANGUE DA CORDONE OMBELICALE
 DONAZIONE SANGUE DA CORDONE OMBELICALE Sono passati molti anni da quando si sono sperimentati i primi trapianti. Oggi trasferire gli organi da un corpo che muore ad uno che può continuare a vivere, non
DONAZIONE SANGUE DA CORDONE OMBELICALE Sono passati molti anni da quando si sono sperimentati i primi trapianti. Oggi trasferire gli organi da un corpo che muore ad uno che può continuare a vivere, non
Che cos è la fibrosi cistica
 La scoperta del gene responsabile della fibrosi cistica ha permesso la messa a punto di un test genetico per identificare il portatore sano del gene della malattia. Si è aperto quindi un importante dibattito
La scoperta del gene responsabile della fibrosi cistica ha permesso la messa a punto di un test genetico per identificare il portatore sano del gene della malattia. Si è aperto quindi un importante dibattito
REGIONE AUTONOMA DELLA SARDEGNA Assessorato dell Igiene e Sanità e dell Assistenza Sociale
 Assessorato dell Igiene e Sanità e dell Assistenza Sociale proposta approvata nella seduta del 9 agosto 2002 Oggetto: Individuazione rete dei presidi regionali per le malattie rare e adempimenti regionali
Assessorato dell Igiene e Sanità e dell Assistenza Sociale proposta approvata nella seduta del 9 agosto 2002 Oggetto: Individuazione rete dei presidi regionali per le malattie rare e adempimenti regionali
Legga le informazioni che seguono e poi risponda alla domanda:
 La scoperta del gene responsabile della fibrosi cistica ha permesso la messa a punto di un test genetico per identificare il portatore sano del gene della malattia. Si è aperto quindi un importante dibattito
La scoperta del gene responsabile della fibrosi cistica ha permesso la messa a punto di un test genetico per identificare il portatore sano del gene della malattia. Si è aperto quindi un importante dibattito
DOTE LAVORO 2012 CASSA INTEGRAZIONE IN DEROGA
 DOTE LAVORO 2012 CASSA INTEGRAZIONE IN DEROGA " " CONTINUIAMO A DOTARCI CONTRO LA CRISI Per il quarto anno consecutivo La Regione del Veneto ha promosso attraverso lo strumento della Dote Lavoro, percorsi
DOTE LAVORO 2012 CASSA INTEGRAZIONE IN DEROGA " " CONTINUIAMO A DOTARCI CONTRO LA CRISI Per il quarto anno consecutivo La Regione del Veneto ha promosso attraverso lo strumento della Dote Lavoro, percorsi
nonostante l emofilia.
 Chi siamo Fondazione Paracelso nasce nel 2004 con la costituzione del Fondo di Solidarietà a favore degli emofilici che negli anni '80 erano stati infettati dall'hiv attraverso i farmaci necessari alla
Chi siamo Fondazione Paracelso nasce nel 2004 con la costituzione del Fondo di Solidarietà a favore degli emofilici che negli anni '80 erano stati infettati dall'hiv attraverso i farmaci necessari alla
Sbarchi in aumento La situazione reale in Italia
 Sbarchi in aumento La situazione reale in Italia La crescente instabilità politico-economica-sociale di tanti Paesi dell'africa sembra avere un effetto immediato sugli sbarchi degli migranti. Il peggioramento
Sbarchi in aumento La situazione reale in Italia La crescente instabilità politico-economica-sociale di tanti Paesi dell'africa sembra avere un effetto immediato sugli sbarchi degli migranti. Il peggioramento
REGIONE LAZIO. Direttore Generale Dott.Vittorio Bonavita. Impegno con il Cittadino del Servizio di Immunoematologia e Medicina Trasfusionale (SIMT)
 REGIONE LAZIO Direttore Generale Dott.Vittorio Bonavita Impegno con il Cittadino del Servizio di Immunoematologia e Medicina Trasfusionale (SIMT) La sede della Sezione di Immunoematologia e Medicina Trasfusionale
REGIONE LAZIO Direttore Generale Dott.Vittorio Bonavita Impegno con il Cittadino del Servizio di Immunoematologia e Medicina Trasfusionale (SIMT) La sede della Sezione di Immunoematologia e Medicina Trasfusionale
superiore verso gli esercizi complementari, le cui quote di mercato risultano comunque largamente inferiori a quelle degli alberghi, che raccolgono
 13. Turismo Il turismo nel comune di Roma si conferma uno dei principali assi di sviluppo del territorio, costituendo, all interno del sistema economico e sociale, un elemento centrale di crescita, che
13. Turismo Il turismo nel comune di Roma si conferma uno dei principali assi di sviluppo del territorio, costituendo, all interno del sistema economico e sociale, un elemento centrale di crescita, che
2. GLI INTERNATIONAL STUDENT A MILANO: QUANTI SONO
 CAPITOLO 2 indagine QuAntitAtivA Maria Teresa Morana 1. INTRODUZIONE Gli studenti stranieri che decidono di studiare nel Comune di per un breve o lungo periodo possono scegliere tra i corsi di istruzione
CAPITOLO 2 indagine QuAntitAtivA Maria Teresa Morana 1. INTRODUZIONE Gli studenti stranieri che decidono di studiare nel Comune di per un breve o lungo periodo possono scegliere tra i corsi di istruzione
I data base e il servizio di medicina trasfusionale: problematiche attuali nella nostra Azienda
 I data base e il servizio di medicina trasfusionale: problematiche attuali nella nostra Azienda Angela Mazzi, Dirigente Medico Servizio di Medicina Trasfusionale Cosa conserviamo c/o il SIMT Emocomponenti
I data base e il servizio di medicina trasfusionale: problematiche attuali nella nostra Azienda Angela Mazzi, Dirigente Medico Servizio di Medicina Trasfusionale Cosa conserviamo c/o il SIMT Emocomponenti
La relazione presenta quanto emerso dalla prima indagine condotta sugli utenti della Biblioteca Isimbardi.
 INTRODUZIONE La relazione presenta quanto emerso dalla prima indagine condotta sugli utenti della Biblioteca Isimbardi. Nel corso di alcuni mesi del 2008 sono state distribuite delle schede anonime, da
INTRODUZIONE La relazione presenta quanto emerso dalla prima indagine condotta sugli utenti della Biblioteca Isimbardi. Nel corso di alcuni mesi del 2008 sono state distribuite delle schede anonime, da
Il quinto e ultimo capitolo quinto è dedicato al caso italiano. Nel nostro paese, la domanda di
 I SINTESI Questo numero di Osservatorio monetario viene interamente dedicato all analisi delle implicazioni derivanti dallo sviluppo della microfinanza. Il primo capitolo descrive le ragioni del successo
I SINTESI Questo numero di Osservatorio monetario viene interamente dedicato all analisi delle implicazioni derivanti dallo sviluppo della microfinanza. Il primo capitolo descrive le ragioni del successo
TITOLO SCREENING ONCOLOGICO DEL TUMORE DEL COLON-RETTO IN PROVINCIA DI RAGUSA: TASSI DI INVITI E ADESIONI PERIODO 2011-2014.
 TITOLO SCREENING ONCOLOGICO DEL TUMORE DEL COLON-RETTO IN PROVINCIA DI RAGUSA: TASSI DI INVITI E ADESIONI PERIODO 2011-2014. Ferrera G.* Cilia S.**, Puglisi C.***, Aprile E., Venga R.. * Resp. U.O. Epidemiologia
TITOLO SCREENING ONCOLOGICO DEL TUMORE DEL COLON-RETTO IN PROVINCIA DI RAGUSA: TASSI DI INVITI E ADESIONI PERIODO 2011-2014. Ferrera G.* Cilia S.**, Puglisi C.***, Aprile E., Venga R.. * Resp. U.O. Epidemiologia
Verifica. Tutto il materiale informativo per gli studenti. Riferimento. Gli studenti svolgono la verifica. Compito. Foglio di esercizio Soluzione
 Livello 1 07 / Il sangue Informazione per gli insegnanti 1/5 Riferimento Tutto il materiale informativo per gli studenti Compito Gli studenti svolgono la verifica. Materiale Soluzione Forma sociale Lavoro
Livello 1 07 / Il sangue Informazione per gli insegnanti 1/5 Riferimento Tutto il materiale informativo per gli studenti Compito Gli studenti svolgono la verifica. Materiale Soluzione Forma sociale Lavoro
Il donatore di emocomponenti e di cellule staminali emopoietiche: attualità e prospettive Compatibilità nel trapianto di CSE e sistema HLA
 Il donatore di emocomponenti e di cellule staminali emopoietiche: attualità e prospettive Compatibilità nel trapianto di CSE e sistema HLA Nicoletta Sacchi Italian Bone Marrow Donor Registry E.O. Ospedali
Il donatore di emocomponenti e di cellule staminali emopoietiche: attualità e prospettive Compatibilità nel trapianto di CSE e sistema HLA Nicoletta Sacchi Italian Bone Marrow Donor Registry E.O. Ospedali
La Comunità Cinese in Italia Rapporto annuale sulla presenza degli immigrati 2013
 La Comunità Cinese in Italia Rapporto annuale sulla presenza degli immigrati 2013 Abstract 2 2013 - Rapporto Comunità XXX in Italia Il Rapporto annuale sul Mercato del lavoro degli Immigrati" promosso
La Comunità Cinese in Italia Rapporto annuale sulla presenza degli immigrati 2013 Abstract 2 2013 - Rapporto Comunità XXX in Italia Il Rapporto annuale sul Mercato del lavoro degli Immigrati" promosso
La prevenzione dei tumori femminili nelle donne straniere
 La prevenzione dei tumori femminili nelle donne straniere Lisa Francovich 1, Lidia Gargiulo 1, Barbara Giordani 2, Paolo Giorgi Rossi 3, Alessio Petrelli 4 1 Istat 2 Servizio Epidemiologia ASLTO3 Regione
La prevenzione dei tumori femminili nelle donne straniere Lisa Francovich 1, Lidia Gargiulo 1, Barbara Giordani 2, Paolo Giorgi Rossi 3, Alessio Petrelli 4 1 Istat 2 Servizio Epidemiologia ASLTO3 Regione
La gestione del Rischio Clinico in Valle d Aosta: consolidamento del metodo FMEA
 La gestione del Rischio Clinico in Valle d Aosta: consolidamento del metodo FMEA Vuillermin Giuliana Berti Pierluigi Ippolito Rita Azienda USL Regione Valle d Aosta Analisi del contesto L Azienda USL della
La gestione del Rischio Clinico in Valle d Aosta: consolidamento del metodo FMEA Vuillermin Giuliana Berti Pierluigi Ippolito Rita Azienda USL Regione Valle d Aosta Analisi del contesto L Azienda USL della
Salute e Scienze Sclerosi multipla, SLA, Alzheimer e Parkinson: novità diagnostiche e terapeutiche
 www.aggm.it Agenzia Giornalistica Global Media Salute e Scienze Sclerosi multipla, SLA, Alzheimer e Parkinson: novità diagnostiche e terapeutiche A Napoli il Congresso mondiale della Società Internazionale
www.aggm.it Agenzia Giornalistica Global Media Salute e Scienze Sclerosi multipla, SLA, Alzheimer e Parkinson: novità diagnostiche e terapeutiche A Napoli il Congresso mondiale della Società Internazionale
VALORI ECONOMICI DELL AGRICOLTURA 1
 VALORI ECONOMICI DELL AGRICOLTURA 1 Secondo i dati forniti dall Eurostat, il valore della produzione dell industria agricola nell Unione Europea a 27 Stati Membri nel 2008 ammontava a circa 377 miliardi
VALORI ECONOMICI DELL AGRICOLTURA 1 Secondo i dati forniti dall Eurostat, il valore della produzione dell industria agricola nell Unione Europea a 27 Stati Membri nel 2008 ammontava a circa 377 miliardi
Guadagnare, lavorare e innovare: il ruolo del riciclo nella green economy
 n. 022 - Martedì 31 Gennaio 2012 Guadagnare, lavorare e innovare: il ruolo del riciclo nella green economy Questo breve report dell Agenzia Europea per l'ambiente prende in esame il ruolo del riciclo nella
n. 022 - Martedì 31 Gennaio 2012 Guadagnare, lavorare e innovare: il ruolo del riciclo nella green economy Questo breve report dell Agenzia Europea per l'ambiente prende in esame il ruolo del riciclo nella
Progetto Atipico. Partners
 Progetto Atipico Partners Imprese Arancia-ICT Arancia-ICT è una giovane società che nasce nel 2007 grazie ad un gruppo di professionisti che ha voluto capitalizzare le competenze multidisciplinari acquisite
Progetto Atipico Partners Imprese Arancia-ICT Arancia-ICT è una giovane società che nasce nel 2007 grazie ad un gruppo di professionisti che ha voluto capitalizzare le competenze multidisciplinari acquisite
Progetto IDENTITAS: Formazione agli operatori di Bilancio di Competenze
 Progetto IDENTITAS: Formazione agli operatori di Bilancio di Competenze Provincia di Roma Anno 2005 Indice Il problema affrontato...3 Obiettivi attesi/risultati raggiunti...3 Soggetti coinvolti...3 Il
Progetto IDENTITAS: Formazione agli operatori di Bilancio di Competenze Provincia di Roma Anno 2005 Indice Il problema affrontato...3 Obiettivi attesi/risultati raggiunti...3 Soggetti coinvolti...3 Il
OCCUPATI E DISOCCUPATI DATI RICOSTRUITI DAL 1977
 24 aprile 2013 OCCUPATI E DISOCCUPATI DATI RICOSTRUITI DAL 1977 L Istat ha ricostruito le serie storiche trimestrali e di media annua dal 1977 ad oggi, dei principali aggregati del mercato del lavoro,
24 aprile 2013 OCCUPATI E DISOCCUPATI DATI RICOSTRUITI DAL 1977 L Istat ha ricostruito le serie storiche trimestrali e di media annua dal 1977 ad oggi, dei principali aggregati del mercato del lavoro,
AMIANTO: quali effetti sulla salute ieri e oggi
 Aggiornamenti in Medicina del Lavoro AMIANTO: quali effetti sulla salute ieri e oggi Aldo Todaro U.O.C. Promozione e protezione salute lavoratori. Fondazione IRCCS CA Granda Ospedale Maggiore Policlinico
Aggiornamenti in Medicina del Lavoro AMIANTO: quali effetti sulla salute ieri e oggi Aldo Todaro U.O.C. Promozione e protezione salute lavoratori. Fondazione IRCCS CA Granda Ospedale Maggiore Policlinico
IL diabetico. Gestione condivisa. Claudio Marengo Marco Comoglio Andrea Pizzini
 IL diabetico anziano Gestione condivisa Claudio Marengo Marco Comoglio Andrea Pizzini SEEd srl C.so Vigevano, 35-10152 Torino Tel. 011.566.02.58 - Fax 011.518.68.92 www.edizioniseed.it [email protected]
IL diabetico anziano Gestione condivisa Claudio Marengo Marco Comoglio Andrea Pizzini SEEd srl C.so Vigevano, 35-10152 Torino Tel. 011.566.02.58 - Fax 011.518.68.92 www.edizioniseed.it [email protected]
5 La popolazione disabile
 5 La popolazione disabile Problematiche inerenti alle fonti dei dati sulla disabilità L Osservatorio per le politiche sociali dell Amministrazione Provinciale ha intrapreso un complesso lavoro di censimento
5 La popolazione disabile Problematiche inerenti alle fonti dei dati sulla disabilità L Osservatorio per le politiche sociali dell Amministrazione Provinciale ha intrapreso un complesso lavoro di censimento
I bisogni della cittadinanza, le risposte di assistenza infermieristica.
 L Infermiere di comunità: prospettive di sviluppo in Lombardia I bisogni della cittadinanza, le risposte di assistenza infermieristica. 12 maggio 2011 Dott. Duilio Loi 1 IL PARADIGMA DELLA COMPLESSITA
L Infermiere di comunità: prospettive di sviluppo in Lombardia I bisogni della cittadinanza, le risposte di assistenza infermieristica. 12 maggio 2011 Dott. Duilio Loi 1 IL PARADIGMA DELLA COMPLESSITA
Progetto Nazionale di Cure Palliative Pediatriche
 Progetto Nazionale di Cure Palliative Pediatriche Ecco la proposta della Fondazione Maruzza Lefebvre D Ovidio, della fondazione Livia Benini, di altre Fondazioni ed Associazioni Italiane e successivamente
Progetto Nazionale di Cure Palliative Pediatriche Ecco la proposta della Fondazione Maruzza Lefebvre D Ovidio, della fondazione Livia Benini, di altre Fondazioni ed Associazioni Italiane e successivamente
1. Il sistema imprenditoriale IL SISTEMA IMPRENDITORIALE
 IL SISTEMA IMPRENDITORIALE 1 1.1 Le imprese attive per settore e forma giuridica Nei primi tre mesi del 2015 risultano iscritte nel Registro Imprese della Camera di Commercio di Lodi 21.784 posizioni,
IL SISTEMA IMPRENDITORIALE 1 1.1 Le imprese attive per settore e forma giuridica Nei primi tre mesi del 2015 risultano iscritte nel Registro Imprese della Camera di Commercio di Lodi 21.784 posizioni,
IL CICLO DI VITA DEL PROGETTO. Elementi essenziali di progetto. Fasi e tappe Gli Approcci
 UNIVERSITA MILANO BICOCCA Corso di laurea di primo livello in servizio sociale anno accademico 2009-2010 Progettare il sociale Prof. Dario A. Colombo IL CICLO DI VITA DEL PROGETTO Elementi essenziali di
UNIVERSITA MILANO BICOCCA Corso di laurea di primo livello in servizio sociale anno accademico 2009-2010 Progettare il sociale Prof. Dario A. Colombo IL CICLO DI VITA DEL PROGETTO Elementi essenziali di
Fonte: elaborazione Unioncamere Lombardia su dati ASIA Istat. Tabella 2: Imprese per attività economica Lombardia
 IL SISTEMA PRODUTTIVO LOMBARDO NEL 2006 SECONDO IL REGISTRO STATISTICO ASIA (giugno 2009) Secondo il registro statistico delle imprese attive e delle loro unità locali (ASIA Imprese e Unità locali) sono
IL SISTEMA PRODUTTIVO LOMBARDO NEL 2006 SECONDO IL REGISTRO STATISTICO ASIA (giugno 2009) Secondo il registro statistico delle imprese attive e delle loro unità locali (ASIA Imprese e Unità locali) sono
COMUNE DI RAVENNA GUIDA ALLA VALUTAZIONE DELLE POSIZIONI (FAMIGLIE, FATTORI, LIVELLI)
 COMUNE DI RAVENNA Il sistema di valutazione delle posizioni del personale dirigente GUIDA ALLA VALUTAZIONE DELLE POSIZIONI (FAMIGLIE, FATTORI, LIVELLI) Ravenna, Settembre 2004 SCHEMA DI SINTESI PER LA
COMUNE DI RAVENNA Il sistema di valutazione delle posizioni del personale dirigente GUIDA ALLA VALUTAZIONE DELLE POSIZIONI (FAMIGLIE, FATTORI, LIVELLI) Ravenna, Settembre 2004 SCHEMA DI SINTESI PER LA
EMERGENZA LAVORO E MICROCREDITO
 EMERGENZA LAVORO E MICROCREDITO il LAVORO: la più grande emergenza del nostro tempo!!! Parte 2, Allegati PROGETTO DISTRETTUALE 2060 A.R. 2014-2015, 2015-2016, 2016-2017 Allegati 1. Il microcredito nel
EMERGENZA LAVORO E MICROCREDITO il LAVORO: la più grande emergenza del nostro tempo!!! Parte 2, Allegati PROGETTO DISTRETTUALE 2060 A.R. 2014-2015, 2015-2016, 2016-2017 Allegati 1. Il microcredito nel
l esperienza degli artigiani
 1 l esperienza degli artigiani 2 Perché una mutua degli artigiani? L Associazione Artigiani si sta impegnando ormai da tempo per trovare soluzione alla questione ormai urgente e presente della copertura
1 l esperienza degli artigiani 2 Perché una mutua degli artigiani? L Associazione Artigiani si sta impegnando ormai da tempo per trovare soluzione alla questione ormai urgente e presente della copertura
COMUNICATO STAMPA. 1 Nel 2009 si era registrato un forte calo dei contribuenti che dichiaravano un reddito da lavoro dipendente (-273 mila).
 COMUNICATO STAMPA Il Dipartimento delle Finanze pubblica le statistiche sulle dichiarazioni delle persone fisiche (IRPEF) relative all'anno d'imposta 2010, a sei mesi dal termine di presentazione (settembre
COMUNICATO STAMPA Il Dipartimento delle Finanze pubblica le statistiche sulle dichiarazioni delle persone fisiche (IRPEF) relative all'anno d'imposta 2010, a sei mesi dal termine di presentazione (settembre
INFEZIONE DA HIV e AIDS
 Dipartimento di Prevenzione Medica Notifica, sorveglianza e controllo delle malattie infettive INFEZIONE DA HIV e AIDS (elaborazione dati dal programma informatizzato Regione Lombardia Mainf e portale
Dipartimento di Prevenzione Medica Notifica, sorveglianza e controllo delle malattie infettive INFEZIONE DA HIV e AIDS (elaborazione dati dal programma informatizzato Regione Lombardia Mainf e portale
Q&Oconsulting s.r.l. Chi siamo Gli ambiti di intervento La struttura divisionale Alcune referenze 2013 > www.qeoconsulting.com
 2013 > Q&Oconsulting s.r.l. Chi siamo Gli ambiti di intervento La struttura divisionale Alcune referenze www.qeoconsulting.com La nostra vision Dal 1996 operiamo nella Consulenza di Direzione Il comportamento
2013 > Q&Oconsulting s.r.l. Chi siamo Gli ambiti di intervento La struttura divisionale Alcune referenze www.qeoconsulting.com La nostra vision Dal 1996 operiamo nella Consulenza di Direzione Il comportamento
LA DIAGNOSTICA MOLECOLARE E I TUMORI DEL SANGUE
 LA DIAGNOSTICA MOLECOLARE E I TUMORI DEL SANGUE UNA NUOVA FRONTIERA NELLA DIAGNOSI DI ALCUNI TUMORI La diagnostica molecolare ha l obiettivo di accertare un ampia varietà di patologie (infettive, oncologiche
LA DIAGNOSTICA MOLECOLARE E I TUMORI DEL SANGUE UNA NUOVA FRONTIERA NELLA DIAGNOSI DI ALCUNI TUMORI La diagnostica molecolare ha l obiettivo di accertare un ampia varietà di patologie (infettive, oncologiche
E nato per dare un impronta educativa/pastorale agli Oratori. Anno 2001
 E nato per dare un impronta educativa/pastorale agli Oratori Anno 2001 Il Forum degli oratori italiani è un organo di coordinamento nazionale degli organismi ecclesiali che dedicano speciale cura all
E nato per dare un impronta educativa/pastorale agli Oratori Anno 2001 Il Forum degli oratori italiani è un organo di coordinamento nazionale degli organismi ecclesiali che dedicano speciale cura all
Costruiamo un futuro sostenibile
 Costruiamo un futuro sostenibile Responsabilità Sociale d Impresa Sommario 2014 Siamo orgogliosi del nostro ruolo nel sistema finanziario globale e siamo fermi nel proposito di svolgere le nostre attività
Costruiamo un futuro sostenibile Responsabilità Sociale d Impresa Sommario 2014 Siamo orgogliosi del nostro ruolo nel sistema finanziario globale e siamo fermi nel proposito di svolgere le nostre attività
ANALISI GRUPPO SANGUIGNO E FATTORE Rh CAPILLARE
 Cod. ID: Data: Paziente: ANALISI GRUPPO SANGUIGNO E FATTORE Rh CAPILLARE Test reagente del Gruppo Sanguigno per test in provetta piastra/vetrino GRUPPO SANGUIGNO COS E IL TEST PER L ANALISI DEL GRUPPO
Cod. ID: Data: Paziente: ANALISI GRUPPO SANGUIGNO E FATTORE Rh CAPILLARE Test reagente del Gruppo Sanguigno per test in provetta piastra/vetrino GRUPPO SANGUIGNO COS E IL TEST PER L ANALISI DEL GRUPPO
CHI DONA SANGUE HA CUORE.
 Tel. e Fax Tel. e Fax Tel. e Fax Tel. e Fax IL E I SUOI COMPONENTI. LE DIVERSE FORME DI DONAZIONE. Il sangue è un tessuto fluido che circola nei vasi sanguigni, rappresenta l 8% del peso corporeo ed è
Tel. e Fax Tel. e Fax Tel. e Fax Tel. e Fax IL E I SUOI COMPONENTI. LE DIVERSE FORME DI DONAZIONE. Il sangue è un tessuto fluido che circola nei vasi sanguigni, rappresenta l 8% del peso corporeo ed è
Ministero dell Istruzione, dell Università e della Ricerca
 Ministero dell Istruzione, dell Università e della Ricerca Ufficio Stampa COMUNICATO STAMPA Scuola, si chiudono con successo le iscrizioni on line: 1,557.601 milioni di domande registrate, il 99,3% Quasi
Ministero dell Istruzione, dell Università e della Ricerca Ufficio Stampa COMUNICATO STAMPA Scuola, si chiudono con successo le iscrizioni on line: 1,557.601 milioni di domande registrate, il 99,3% Quasi
AVIS COMUNALE ROMA & AVIS PROVINCIALE DI ROMA
 AVIS COMUNALE ROMA & AVIS PROVINCIALE DI ROMA Il nostro progetto non nasce da una nostra idea vera e propria ma è piuttosto la realizzazione del progetto del Servizio Civile Nazionale adattato alla nostra
AVIS COMUNALE ROMA & AVIS PROVINCIALE DI ROMA Il nostro progetto non nasce da una nostra idea vera e propria ma è piuttosto la realizzazione del progetto del Servizio Civile Nazionale adattato alla nostra
Dato atto che con delibera 1235 del 22.09.1999 il Consiglio regionale ha adottato il Piano Sanitario Regionale per il triennio 1999 2002;
 Page 1 of 8 Prot. N. (OSP/05/33015) LA GIUNTA DELLA REGIONE EMILIA-ROMAGNA Dato atto che con delibera 1235 del 22.09.1999 il Consiglio regionale ha adottato il Piano Sanitario Regionale per il triennio
Page 1 of 8 Prot. N. (OSP/05/33015) LA GIUNTA DELLA REGIONE EMILIA-ROMAGNA Dato atto che con delibera 1235 del 22.09.1999 il Consiglio regionale ha adottato il Piano Sanitario Regionale per il triennio
Il diritto di cittadinanza in Europa
 Il diritto di cittadinanza in Europa Il diritto e le politiche della cittadinanza sono uno strumento essenziale per regolare i processi di integrazione a lungo termine. Perciò è importante fare il punto
Il diritto di cittadinanza in Europa Il diritto e le politiche della cittadinanza sono uno strumento essenziale per regolare i processi di integrazione a lungo termine. Perciò è importante fare il punto
LO STATO DELLA RICERCA SANITARIA IN ITALIA
 SAS Campus 2011 - Università di Milano-Bicocca, 22 novembre Business Intelligence e Analytics nell università, nel business e nel government per la crescita del Sistema Paese LO STATO DELLA RICERCA SANITARIA
SAS Campus 2011 - Università di Milano-Bicocca, 22 novembre Business Intelligence e Analytics nell università, nel business e nel government per la crescita del Sistema Paese LO STATO DELLA RICERCA SANITARIA
Grado di istruzione della popolazione faentina residente al Censimento 2001
 Grado di istruzione della popolazione faentina residente al Censimento 2001 Sintesi del rapporto Possiamo affermare di essere un popolo più istruito rispetto al 1991. Aumentano le persone in possesso del
Grado di istruzione della popolazione faentina residente al Censimento 2001 Sintesi del rapporto Possiamo affermare di essere un popolo più istruito rispetto al 1991. Aumentano le persone in possesso del
Coinvolgimento delle comunità immigrate e ruolo delle associazioni. Chi sono le associazioni?
 Informazione, educazione ed empowerment del paziente e delle comunità Coinvolgimento delle comunità immigrate e ruolo delle associazioni Chi sono le associazioni? Le associazioni di stranieri al 31/12/2008
Informazione, educazione ed empowerment del paziente e delle comunità Coinvolgimento delle comunità immigrate e ruolo delle associazioni Chi sono le associazioni? Le associazioni di stranieri al 31/12/2008
CHI SIAMO. BeOn è una società di consulenza italiana ad alta specializzazione in ambito di valutazione, sviluppo e formazione delle risorse umane.
 www.beon-dp.com Operiamo in ambito di: Sviluppo Assessment e development Center Valutazione e feedback a 360 Formazione Coaching CHI SIAMO BeOn è una società di consulenza italiana ad alta specializzazione
www.beon-dp.com Operiamo in ambito di: Sviluppo Assessment e development Center Valutazione e feedback a 360 Formazione Coaching CHI SIAMO BeOn è una società di consulenza italiana ad alta specializzazione
Tutta la Milano possibile La nuova residenzialità, l uso sociale dell abitare
 Tutta la Milano possibile La nuova residenzialità, l uso sociale dell abitare Il progetto «A casa lontani da casa» Guido Arrigoni Vice Presidente Associazione PROMETEO Onlus I partner Il progetto «A casa
Tutta la Milano possibile La nuova residenzialità, l uso sociale dell abitare Il progetto «A casa lontani da casa» Guido Arrigoni Vice Presidente Associazione PROMETEO Onlus I partner Il progetto «A casa
Da che cosa è composto il sangue?
 DONAZIONE DEL SANGUE La donazione di sangue non è solo un gesto di altruismo, ma soprattutto una necessità per l intera collettività. A tutt oggi non esiste sangue artificiale, cioè un sostituto con le
DONAZIONE DEL SANGUE La donazione di sangue non è solo un gesto di altruismo, ma soprattutto una necessità per l intera collettività. A tutt oggi non esiste sangue artificiale, cioè un sostituto con le
SUBROGALIA acquisisce la Clinica Istituto di Studi Genetici e di Riproduzione Assistita IEGRA
 MAGGIO 2014 SUBROGALIA acquisisce la Clinica Istituto di Studi Genetici e di Riproduzione Assistita IEGRA Al fine di offrire tutte le alternative di servizio ai propri clienti, SUBROGALIA ha acquisito
MAGGIO 2014 SUBROGALIA acquisisce la Clinica Istituto di Studi Genetici e di Riproduzione Assistita IEGRA Al fine di offrire tutte le alternative di servizio ai propri clienti, SUBROGALIA ha acquisito
Otto Principi sulla Gestione per la Qualità previsti dalla ISO 9000:2005
 Questionario di Autovalutazione di un Sistema di Gestione per la Qualità verso: Otto Principi sulla Gestione per la Qualità previsti dalla ISO 9000:2005 newsletter TECSE N. 02- Febbraio 2012 (Allegato
Questionario di Autovalutazione di un Sistema di Gestione per la Qualità verso: Otto Principi sulla Gestione per la Qualità previsti dalla ISO 9000:2005 newsletter TECSE N. 02- Febbraio 2012 (Allegato
Organizzazione e gestione delle Malattie Rare nella Regione Emilia-Romagna: esperienza e prospettive
 Organizzazione e gestione delle Malattie Rare nella Regione Emilia-Romagna: esperienza e prospettive Elisa Rozzi Servizio Presidi Ospedalieri Direzione Generale Sanità e Politiche Sociali Assessorato Politiche
Organizzazione e gestione delle Malattie Rare nella Regione Emilia-Romagna: esperienza e prospettive Elisa Rozzi Servizio Presidi Ospedalieri Direzione Generale Sanità e Politiche Sociali Assessorato Politiche
VALUTAZIONE COMPARATIVA TRA DUE SISTEMI PER LA RILEVAZIONE DELL INFEZIONE DA TREPONEMA PALLIDO Calabrese S., Digiacomo L., Cassarono G., Muriana S.
 VALUTAZIONE COMPARATIVA TRA DUE SISTEMI PER LA RILEVAZIONE DELL INFEZIONE DA TREPONEMA PALLIDO Calabrese S., Digiacomo L., Cassarono G., Muriana S., Godani A., Bonomo P. Scopo: Verifi care le performance
VALUTAZIONE COMPARATIVA TRA DUE SISTEMI PER LA RILEVAZIONE DELL INFEZIONE DA TREPONEMA PALLIDO Calabrese S., Digiacomo L., Cassarono G., Muriana S., Godani A., Bonomo P. Scopo: Verifi care le performance
GLI ENTI D EROGAZIONE IN ITALIA
 GLI ENTI D EROGAZIONE IN ITALIA Sono 4.388 gli enti di diritto privato che hanno indicato come attività prevalente o esclusiva l erogazione di sussidi a individui, piuttosto che quella di contributi a
GLI ENTI D EROGAZIONE IN ITALIA Sono 4.388 gli enti di diritto privato che hanno indicato come attività prevalente o esclusiva l erogazione di sussidi a individui, piuttosto che quella di contributi a
1.0 POLITICA AZIENDALE PER LA SALUTE E LA SICUREZZA SUL LAVORO
 Pagina 1 di 5 1.0 POLITICA AZIENDALE PER LA SALUTE E LA SICUREZZA SUL LAVORO (rif. punto 4.2 BS OHSAS 18001:2007) 1.1 SCOPO La dichiarazione di politica per la salute e la sicurezza nei luoghi di lavoro,
Pagina 1 di 5 1.0 POLITICA AZIENDALE PER LA SALUTE E LA SICUREZZA SUL LAVORO (rif. punto 4.2 BS OHSAS 18001:2007) 1.1 SCOPO La dichiarazione di politica per la salute e la sicurezza nei luoghi di lavoro,
IL TURISMO IN CIFRE negli esercizi alberghieri di Roma e Provincia Gennaio 2009 Ge nnai o 2009
 Ge nnai o 2009 1. L andamento generale negli alberghi della Provincia di Roma L anno 2009 inizia con il segno negativo della domanda turistica rispetto all inizio dell anno precedente. Gli arrivi complessivi
Ge nnai o 2009 1. L andamento generale negli alberghi della Provincia di Roma L anno 2009 inizia con il segno negativo della domanda turistica rispetto all inizio dell anno precedente. Gli arrivi complessivi
Merchant Banking NSW. 26 Giugno 2014. Strettamente riservato e confidenziale
 Merchant Banking NSW Strettamente riservato e confidenziale 26 Giugno 2014 Tab 1 - Il mercato del capitale di rischio Elevata liquidità disponibile a livello globale e continua ricerca di alternative investment
Merchant Banking NSW Strettamente riservato e confidenziale 26 Giugno 2014 Tab 1 - Il mercato del capitale di rischio Elevata liquidità disponibile a livello globale e continua ricerca di alternative investment
I percorsi con la scuola dei bambini e dei ragazzi adottati e delle loro famiglie
 L impegno per le famiglie adottive in Toscana. Lavorare insieme per favorire l inserimento e l accoglienza a scuola I percorsi con la scuola dei bambini e dei ragazzi adottati e delle loro famiglie 1 Adottare
L impegno per le famiglie adottive in Toscana. Lavorare insieme per favorire l inserimento e l accoglienza a scuola I percorsi con la scuola dei bambini e dei ragazzi adottati e delle loro famiglie 1 Adottare
Epidemiologia della malattia nodulare,delle tiroiditi e delle neoplasie della tiroide
 Le Malattie della Tiroide A.S.L. AL- Casale Monferrato 19-03- 2011 Epidemiologia della malattia nodulare,delle tiroiditi e delle neoplasie della tiroide Anna Caramellino Massimo Miglietta Perché pazienti
Le Malattie della Tiroide A.S.L. AL- Casale Monferrato 19-03- 2011 Epidemiologia della malattia nodulare,delle tiroiditi e delle neoplasie della tiroide Anna Caramellino Massimo Miglietta Perché pazienti
PIANO REGIONALE DELLA PREVENZIONE 2014-2018
 MACRO OBIETTIVO 7 Codici indicatori: 7.6.1 PIANO REGIONALE DELLA PREVENZIONE 2014-2018 Programma: Mantenimento e Implementazione del Sistema per supportare le istituzioni scolastiche nella promozione della
MACRO OBIETTIVO 7 Codici indicatori: 7.6.1 PIANO REGIONALE DELLA PREVENZIONE 2014-2018 Programma: Mantenimento e Implementazione del Sistema per supportare le istituzioni scolastiche nella promozione della
delle Partecipate e dei fornitori
 ... I pagamenti della Pubblica Amministrazione,......... L u g l i o 2 0 1 4 Debito PA: miglioramenti più contenuti nel primo trimestre... Sintesi dei risultati C ontinuano nei primi tre mesi del 2014
... I pagamenti della Pubblica Amministrazione,......... L u g l i o 2 0 1 4 Debito PA: miglioramenti più contenuti nel primo trimestre... Sintesi dei risultati C ontinuano nei primi tre mesi del 2014
L ATI composta da Associazione Nuovi Lavori e BIC Puglia s.c.a.r.l., nell ambito del progetto URLO Una rete per le opportunità, PROMUOVE
 L ATI composta da Associazione Nuovi Lavori e BIC Puglia s.c.a.r.l., nell ambito del progetto URLO Una rete per le opportunità, PROMUOVE un PROTOCOLLO D INTESA tra CONSIGLIERA PARITÀ PROVINCIALE DONNE
L ATI composta da Associazione Nuovi Lavori e BIC Puglia s.c.a.r.l., nell ambito del progetto URLO Una rete per le opportunità, PROMUOVE un PROTOCOLLO D INTESA tra CONSIGLIERA PARITÀ PROVINCIALE DONNE
COME NASCE E COME OPERA BANCO FARMACEUTICO
 STORIA L Associazione Banco Farmaceutico onlus nasce nel 2000 dall incontro tra la professionalità di Federfarma e l esperienza nel settore sociale di Compagnia delle Opere. Nel 2008, dall esigenza di
STORIA L Associazione Banco Farmaceutico onlus nasce nel 2000 dall incontro tra la professionalità di Federfarma e l esperienza nel settore sociale di Compagnia delle Opere. Nel 2008, dall esigenza di
LA POPOLAZIONE STRANIERA RESIDENTE IN ITALIA AL 1/1/2006 A CONFRONTO CON QUELLA RESIDENTE A FAENZA
 COMUNE DI FAENZA SETTORE SVILUPPO ECONOMICO Servizio Aziende e Partecipazioni comunali LA POPOLAZIONE STRANIERA RESIDENTE IN ITALIA AL 1/1/2006 A CONFRONTO CON QUELLA RESIDENTE A FAENZA Edizione 1/ST/st/26.10.2006
COMUNE DI FAENZA SETTORE SVILUPPO ECONOMICO Servizio Aziende e Partecipazioni comunali LA POPOLAZIONE STRANIERA RESIDENTE IN ITALIA AL 1/1/2006 A CONFRONTO CON QUELLA RESIDENTE A FAENZA Edizione 1/ST/st/26.10.2006
I CONTRATTI DI RENDIMENTO ENERGETICO:
 SERVIZI I CONTRATTI DI RENDIMENTO ENERGETICO: OPPORTUNITÀ ED ESPERIENZA Maurizio Bottaini Federesco (Federazione Nazionale delle Esco) Federesco BEST PRACTICE ENERGY SERVICE COMPANY, quali operatori di
SERVIZI I CONTRATTI DI RENDIMENTO ENERGETICO: OPPORTUNITÀ ED ESPERIENZA Maurizio Bottaini Federesco (Federazione Nazionale delle Esco) Federesco BEST PRACTICE ENERGY SERVICE COMPANY, quali operatori di
Quadro dei consumi energetici
 Quadro dei consumi energetici La situazione nazionale Il quadro dei consumi energetici nazionali degli ultimi anni delinea una sostanziale stazionarietà per quanto riguarda il settore industriale e una
Quadro dei consumi energetici La situazione nazionale Il quadro dei consumi energetici nazionali degli ultimi anni delinea una sostanziale stazionarietà per quanto riguarda il settore industriale e una
FORMULARIO DI RICHIESTA S U P P O R T Versione 2007 Sostegno ai progetti di promozione della salute realizzati da immigrati e immigrate
 FORMULARIO DI RICHIESTA S U P P O R T Versione 2007 Sostegno ai progetti di promozione della salute realizzati da immigrati e immigrate Nome del progetto Prevenzione Africa Richiedente Nome Imed Omrane
FORMULARIO DI RICHIESTA S U P P O R T Versione 2007 Sostegno ai progetti di promozione della salute realizzati da immigrati e immigrate Nome del progetto Prevenzione Africa Richiedente Nome Imed Omrane
Il Il Programma di Azione Nazionale di lotta alla siccità e alla desertificazione
 Il Il Programma di Azione Nazionale di lotta alla siccità e alla desertificazione Rosanna Bissoli Servizio Tutela e Risanamento Risorsa Acqua Assessorato Ambiente e Sviluppo Sostenibile Bologna, 15 ottobre
Il Il Programma di Azione Nazionale di lotta alla siccità e alla desertificazione Rosanna Bissoli Servizio Tutela e Risanamento Risorsa Acqua Assessorato Ambiente e Sviluppo Sostenibile Bologna, 15 ottobre
Nuovo anno, nuovi progetti
 Nuovo anno, nuovi progetti Valorizzare il contatto diretto con i cittadini Annarosa Racca Presidente Federfarma Milano, 3/12/2015 2015: anno di Expo Nel 2015 le farmacie milanesi sono state fortemente
Nuovo anno, nuovi progetti Valorizzare il contatto diretto con i cittadini Annarosa Racca Presidente Federfarma Milano, 3/12/2015 2015: anno di Expo Nel 2015 le farmacie milanesi sono state fortemente
COMUNE DI COMO. I MATRIMONI NEL COMUNE DI COMO Presentazione dei dati dal 2000 al 2004. (1 Edizione)
 COMUNE DI COMO I MATRIMONI NEL COMUNE DI COMO Presentazione dei dati dal 2000 al 2004 (1 Edizione) Settore Statistica - Agosto 2007 I MATRIMONI NEL COMUNE DI COMO Presentazione dei dati dal 2000 al 2004
COMUNE DI COMO I MATRIMONI NEL COMUNE DI COMO Presentazione dei dati dal 2000 al 2004 (1 Edizione) Settore Statistica - Agosto 2007 I MATRIMONI NEL COMUNE DI COMO Presentazione dei dati dal 2000 al 2004
PARTNER DI PROGETTO. Università degli Studi di Palermo Dipartimento di Ingegneria Industriale
 PARTNER DI PROGETTO Il raggruppamento dei soggetti attuatori è altamente qualificato. Da una parte, la presenza di quattro aziende del settore ICT garantirà, ognuna per le proprie aree di competenza, un
PARTNER DI PROGETTO Il raggruppamento dei soggetti attuatori è altamente qualificato. Da una parte, la presenza di quattro aziende del settore ICT garantirà, ognuna per le proprie aree di competenza, un
ISTITUTO PROFESSIONALE
 Via Resistenza,800 41058 Vignola (Modena) tel. 059 771195 fax. 059 764354 e-mail: [email protected] www.istitutolevi.it ISTITUTO PROFESSIONALE MANUTENZIONE E ASSISTENZA TECNICA (con qualifica di
Via Resistenza,800 41058 Vignola (Modena) tel. 059 771195 fax. 059 764354 e-mail: [email protected] www.istitutolevi.it ISTITUTO PROFESSIONALE MANUTENZIONE E ASSISTENZA TECNICA (con qualifica di
